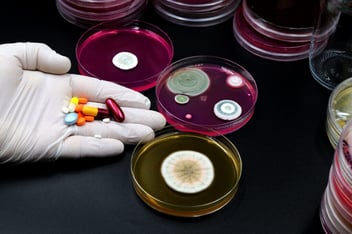

Editor's Press Release of the Month | World-First Mobile CT to Be Developed for Regional Healthcare Micro-X
The selection of Micro-X’s announcement as the Press Release of the Month is a testament to its significance in medical technology innovation, strategic communication, and the global impact of an Australian company from Adelaide. Let’s unpack why this press release stands out:
1. Groundbreaking medical innovation
Micro-X’s development of a world-first full-body mobile CT scanner represents a major leap in medical imaging. By leveraging its proprietary X-ray technology, the company is pushing the boundaries of what is possible in diagnostic imaging, particularly in rural healthcare. This pioneering approach is the key reason why this announcement captured attention. We call this news value #IMPACT.
2. Clear and compelling messaging
The press release effectively communicates the complexity of the innovation in a clear and engaging manner. The integration of Micro-X’s advanced X-ray technology with a vehicle-based delivery system is explained concisely, making it accessible to a broad audience—including media, healthcare professionals, investors, and policymakers. Strong quotes from company executives further reinforce the strategic importance of the development.
3. High-level government backing
Receiving over US$16 million in funding from the U.S. Advanced Research Projects Agency for Health (ARPA-H) further highlights the credibility and significance of Micro-X’s project. This government endorsement not only strengthens the company’s market position but also signals confidence in its ability to revolutionise medical diagnostics beyond hospital settings.
4. Real-world impact on healthcare accessibility
With a focus on rural and remote healthcare access, Micro-X’s innovation directly addresses a critical global challenge. The potential to provide hospital-grade imaging in underserved areas positions this project as a game-changer, aligning with broader efforts to enhance healthcare equity. This aspect enhances the press release’s relevance and newsworthiness.
5. Strategic use of multimedia
The inclusion of images enhances engagement across media channels. Visual storytelling strengthens the impact of the announcement, making it more appealing to journalists, stakeholders, and the public.
6. Global distribution and reach
Micro-X, an Australian company, leveraged international press distribution services to ensure widespread dissemination of its groundbreaking news. Utilising the leading global press release distribution platforms, the company strategically positioned its press release for maximum visibility. This approach not only amplified its reach within the healthcare and investment sectors but also ensured that key global stakeholders, including media outlets and government agencies, received timely access to this important development.
Medianet partners with news agencies in Asia and across the globe. Talk to us about taking your press release beyond the domestic market with our global press release distribution.
Micro-X’s press release exemplifies best-in-class communication, seamlessly blending technical achievement with compelling storytelling. It's selection as the Press Release of the Month recognises both the innovation it showcases and the excellence in its delivery.
Want to amplify your organisation’s PR strategy? Contact Medianet today.
About the Author